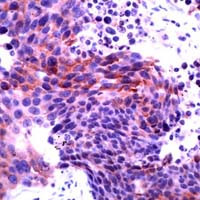
AKT1/AKT2 Antibody in Immunohistochemistry (IHC)

Search
Invitrogen
AKT1/AKT2 Polyclonal Antibody
{{$productOrderCtrl.translations['antibody.pdp.commerceCard.promotion.promotions']}}
{{$productOrderCtrl.translations['antibody.pdp.commerceCard.promotion.viewpromo']}}
{{$productOrderCtrl.translations['antibody.pdp.commerceCard.promotion.promocode']}}: {{promo.promoCode}} {{promo.promoTitle}} {{promo.promoDescription}}. {{$productOrderCtrl.translations['antibody.pdp.commerceCard.promotion.learnmore']}}
产品信息
PA1-37053
宿主/亚型
分类
类型
抗原
偶联物
形式
保存条件
运输条件
RRID
产品详细信息
This antibody is predicted to react with bovine, chicken, canine, amphibian, mouse, porcine and rat based on sequence homology.
Heat-mediated antigen retrieval is recommended prior to staining, using a 10mM citrate buffer, pH 6.0, for 10 minutes followed by cooling at room temperature for 20 min. Following antigen retrieval, incubate samples with primary antibody for 30 min at room temperature. A suggested positive control is lung carcinoma.
靶标信息
AKT1 is one of 3 closely related serine/threonine-protein kinases (AKT1, AKT2 and AKT3) called the AKT kinase, and which regulate many processes including metabolism, proliferation, cell survival, growth and angiogenesis. This is mediated through serine and/or threonine phosphorylation of a range of downstream substrates. Over 100 substrate candidates have been reported so far, but for most of them, no isoform specificity has been reported. AKT is responsible of the regulation of glucose uptake by mediating insulin-induced translocation of the SLC2A4/GLUT4 glucose transporter to the cell surface. Phosphorylation of PTPN1 at 'Ser-50' negatively modulates its phosphatase activity preventing dephosphorylation of the insulin receptor and the attenuation of insulin signaling. Phosphorylation of TBC1D4 triggers the binding of this effector to inhibitory 14-3-3 proteins, which is required for insulin-stimulated glucose transport. AKT regulates also the storage of glucose in the form of glycogen by phosphorylating GSK3A at 'Ser-21' and GSK3B at 'Ser-9', resulting in inhibition of its kinase activity.
仅用于科研。不用于诊断过程。未经明确授权不得转售。